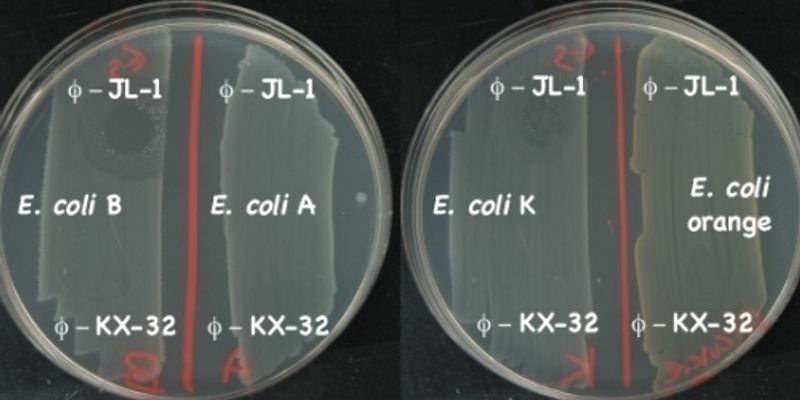

Phage Typing
Phage Typing: is a method used for detecting single strains of bacteria. It is used to trace the source of outbreaks of infections. The viruses that infect bacteria are called bacteriophages and some of these can only infect a single strain of bacteria.
What's Popular in Phage Typing
-
AUG 17, 2023MicrobiologyIt's been generally assumed that RNA molecules and proteins have only limited or transient interactions in cells, li ...Written By: Carmen LeitchJUL 17, 2023Drug Discovery & DevelopmentIntroduction Antibodies are the ideal therapeutic biomolecules due to their ability to bind to a variety of targets with ...MAR 07, 2023Genetics & GenomicsAntibiotics can destroy many types of bacteria, but increasingly, bacterial pathogens are gaining resistance to many com ...Written By: Carmen LeitchDEC 20, 2022MicrobiologyFor decades, people relied on antibiotics to eliminate bacterial infections, and for a long time, those antibiotics work ...Written By: Carmen LeitchDEC 01, 2022Genetics & GenomicsThe CRISPR/Cas9 gene editing tool has changed biomedical research, and has even been used in the clinic in a few cases t ...Written By: Carmen Leitch
AUG 17, 2023
Microbiology
It's been generally assumed that RNA molecules and proteins have only limited or transient interactions in cells, li
...
Written By:
Carmen Leitch
JUL 17, 2023
Drug Discovery & Development
Introduction Antibodies are the ideal therapeutic biomolecules due to their ability to bind to a variety of targets with
...
MAR 07, 2023
Genetics & Genomics
Antibiotics can destroy many types of bacteria, but increasingly, bacterial pathogens are gaining resistance to many com
...
Written By:
Carmen Leitch
DEC 20, 2022
Microbiology
For decades, people relied on antibiotics to eliminate bacterial infections, and for a long time, those antibiotics work
...
Written By:
Carmen Leitch
DEC 01, 2022
Genetics & Genomics
The CRISPR/Cas9 gene editing tool has changed biomedical research, and has even been used in the clinic in a few cases t
...
Written By:
Carmen Leitch
NOV 08, 2022
Drug Discovery & Development
Cystic fibrosis (CF) affects over 100,000 people worldwide and is caused by one of several known mutations in the CFTR (
...
Written By:
Anusha Naganathan
AUG 03, 2022
Microbiology
The discovery of giant viruses, some of which infect bacterial cells, has changed what we knew about microbes. Image cre
...
Written By:
Carmen Leitch
FEB 28, 2022
Microbiology
Trillions of microbes live in our gastrointestinal tracts, and all of those cells have their own genomes are proteins, m
...
Written By:
Carmen Leitch
JAN 31, 2022
Cell & Molecular Biology
The human immune system is incredibly complex. Scientists studying its function have discovered that a group of proteins
...
Written By:
Carmen Leitch
-
Screening to identify all known viruses and other pathogenic microorganisms including bacteria, fungus and parasites in human tumor tissues will provide a more comprehensive understanding of...Speaker: Erle Robertson, PhD
Screening to identify all known viruses and other pathogenic microorganisms including bacteria, fungus and parasites in human tumor tissues will provide a more comprehensive understanding of...
Speaker:
Erle Robertson, PhD
-
JUL 22, 2021 | 5:00 AM PDTGene and cell engineering advances have influenced almost all branches of life sciences. From the lab to the clinic, innovative gene synthesis technologies and gene editing tools have transf...MAY 08, 2019 | 6:00 AM PDTC.E. CREDITSLabroots and the Genetics and Genomics planning committee are excited to announce they will be hosting the 7th Annual Event in the Genetics and Genomics Virtual Event Series on May 8-9, 2019....SEP 12, 2018 | 6:00 AM PDTJoin Labroots in bringing the microbiology research community together at the 3rd Annual Event in the Microbiology and Immunology Virtual Event Series! During the free...SEP 13, 2017 | 6:00 AM PDTThe Labroots Microbiology & Immunology Virtual Event Series 2017 is now On Demand! Join us in bringing the Microbiology research community together online in discovering new concepts,...MAY 24, 2017 | 6:00 AM PDTThe Laboratory Automation 2017 virtual conference is available On-Demand! Laboratory automation is a multi-disciplinary approach benefiting from technologies in the lab that facilit...
JUL 22, 2021
| 5:00 AM PDT
Gene and cell engineering advances have influenced almost all branches of life sciences. From the lab to the clinic, innovative gene synthesis technologies and gene editing tools have transf...
MAY 08, 2019
| 6:00 AM PDT
C.E. CREDITS
Labroots and the Genetics and Genomics planning committee are excited to announce they will be hosting the 7th Annual Event in the Genetics and Genomics Virtual Event Series on May 8-9, 2019....
SEP 12, 2018
| 6:00 AM PDT
Join Labroots in bringing the microbiology research community together at the 3rd Annual Event in the Microbiology and Immunology Virtual Event Series! During the free...
SEP 13, 2017
| 6:00 AM PDT
The Labroots Microbiology & Immunology Virtual Event Series 2017 is now On Demand! Join us in bringing the Microbiology research community together online in discovering new concepts,...
MAY 24, 2017
| 6:00 AM PDT
The Laboratory Automation 2017 virtual conference is available On-Demand! Laboratory automation is a multi-disciplinary approach benefiting from technologies in the lab that facilit...
JAN 25, 2017
| 5:00 AM PST
The Abcam virtual exhibition is temporarily closed. It will re-open shortly. Please check back October 25th. All webinars will be available for viewing at that time.Get the su...
OCT 29, 2014
| 6:00 AM PDT
Welcome to the 2nd Annual Event in the Cancer: Research, Discovery and Therapeutics Virtual Event Series!...
AUG 21, 2013
| 6:00 AM PDT
C.E. CREDITS
The theme of this conference is a range of genetics and genomics topics such as RNAi, Next-generation sequencing, Cancer research, Sequencing, Genome-wide association studies GWAS, Epigenetic...